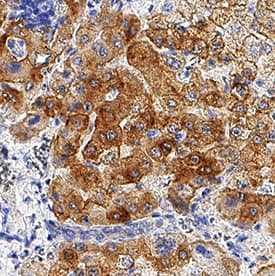
ASGR2 antibody in Human Liver by Immunohistochemistry (IHC-P).

Human ASGR2 Antibody
R&D Systems, part of Bio-Techne | Catalog # MAB9970


Key Product Details
Species Reactivity
Applications
Label
Antibody Source
Product Specifications
Immunogen
Gln80-Ala311
Accession # P07307
Specificity
Clonality
Host
Isotype
Scientific Data Images for Human ASGR2 Antibody
Detection of Human ASGR2 by Western Blot.
Western blot shows lysates of human liver tissue. PVDF membrane was probed with 2 µg/mL of Rabbit Anti-Human ASGR2 Monoclonal Antibody (Catalog # MAB9970) followed by HRP-conjugated Anti-Rabbit IgG Secondary Antibody (Catalog # HAF008). A specific band was detected for ASGR2 at approximately 45 kDa (as indicated). This experiment was conducted under reducing conditions and using Immunoblot Buffer Group 1.Detection of ASGR2 in HEK293 Human Cell Line Transfected with Human ASGR2 and eGFP by Flow Cytometry.
HEK293 human embryonic kidney cell line transfected with (A) human ASGR2 or (B) irrelevant transfectants and eGFP was stained with Mouse Anti-Human ASGR2 Monoclonal Antibody (Catalog # MAB9970) followed by APC-conjugated Anti-Rabbit IgG Secondary Antibody (Catalog # F0111). Quadrant markers were set based on control antibody staining (Catalog # MAB1050). View our protocol for Staining Membrane-associated Proteins.ASGR2 in Human Liver.
ASGR2 was detected in immersion fixed paraffin-embedded sections of human liver using Rabbit Anti-Human ASGR2 Monoclonal Antibody (Catalog # MAB9970) at 1 µg/mL for 1 hour at room temperature followed by incubation with the Anti-Rabbit IgG VisUCyte™ HRP Polymer Antibody (Catalog # VC003). Tissue was stained using DAB (brown) and counterstained with hematoxylin (blue). Specific staining was localized to cytoplasm in hepatocytes. View our protocol for IHC Staining with VisUCyte HRP Polymer Detection Reagents.Applications for Human ASGR2 Antibody
Flow Cytometry
Sample: HEK293 Human Cell Line Transfected with Human ASGR2 and eGFP
Immunohistochemistry
Sample: Immersion fixed paraffin-embedded sections of human liver
Western Blot
Sample: Human liver tissue
Reviewed Applications
Read 1 review rated 5 using MAB9970 in the following applications:
Formulation, Preparation, and Storage
Purification
Reconstitution
Formulation
Shipping
Stability & Storage
- 12 months from date of receipt, -20 to -70 °C, as supplied.
- 1 month, 2 to 8 °C under sterile conditions after opening.
- 6 months, -20 to -70 °C under sterile conditions after opening.
Background: ASGR2
Asialoglycoprotein receptor 2 (ASGR2) is a subunit of the Asialoglycoprotein receptor. The asialoglycoprotein receptor is a hetero-oligomeric protein composed of major and minor subunits, which are encoded by different genes. The protein encoded by this gene is the less abundant minor subunit. The asialoglycoprotein receptor may facilitate hepatic infection by multiple viruses including hepatitis B, and is also a target for liver-specific drug delivery. Expressed on hepatocytes, the Asialoglycoprotein receptor mediates endocytosis and lysosomal degradation of glycoproteins to mediate serum glycoprotein homeostasis. The ASGR receptor binds plasma glycoproteins which have had the terminal sialic acid residue removed. An alternatively spliced variant, H2, which can be shed, has been proposed as a marker for liver fibrosis.
Long Name
Alternate Names
Gene Symbol
UniProt
Additional ASGR2 Products
Product Documents for Human ASGR2 Antibody
Product Specific Notices for Human ASGR2 Antibody
For research use only